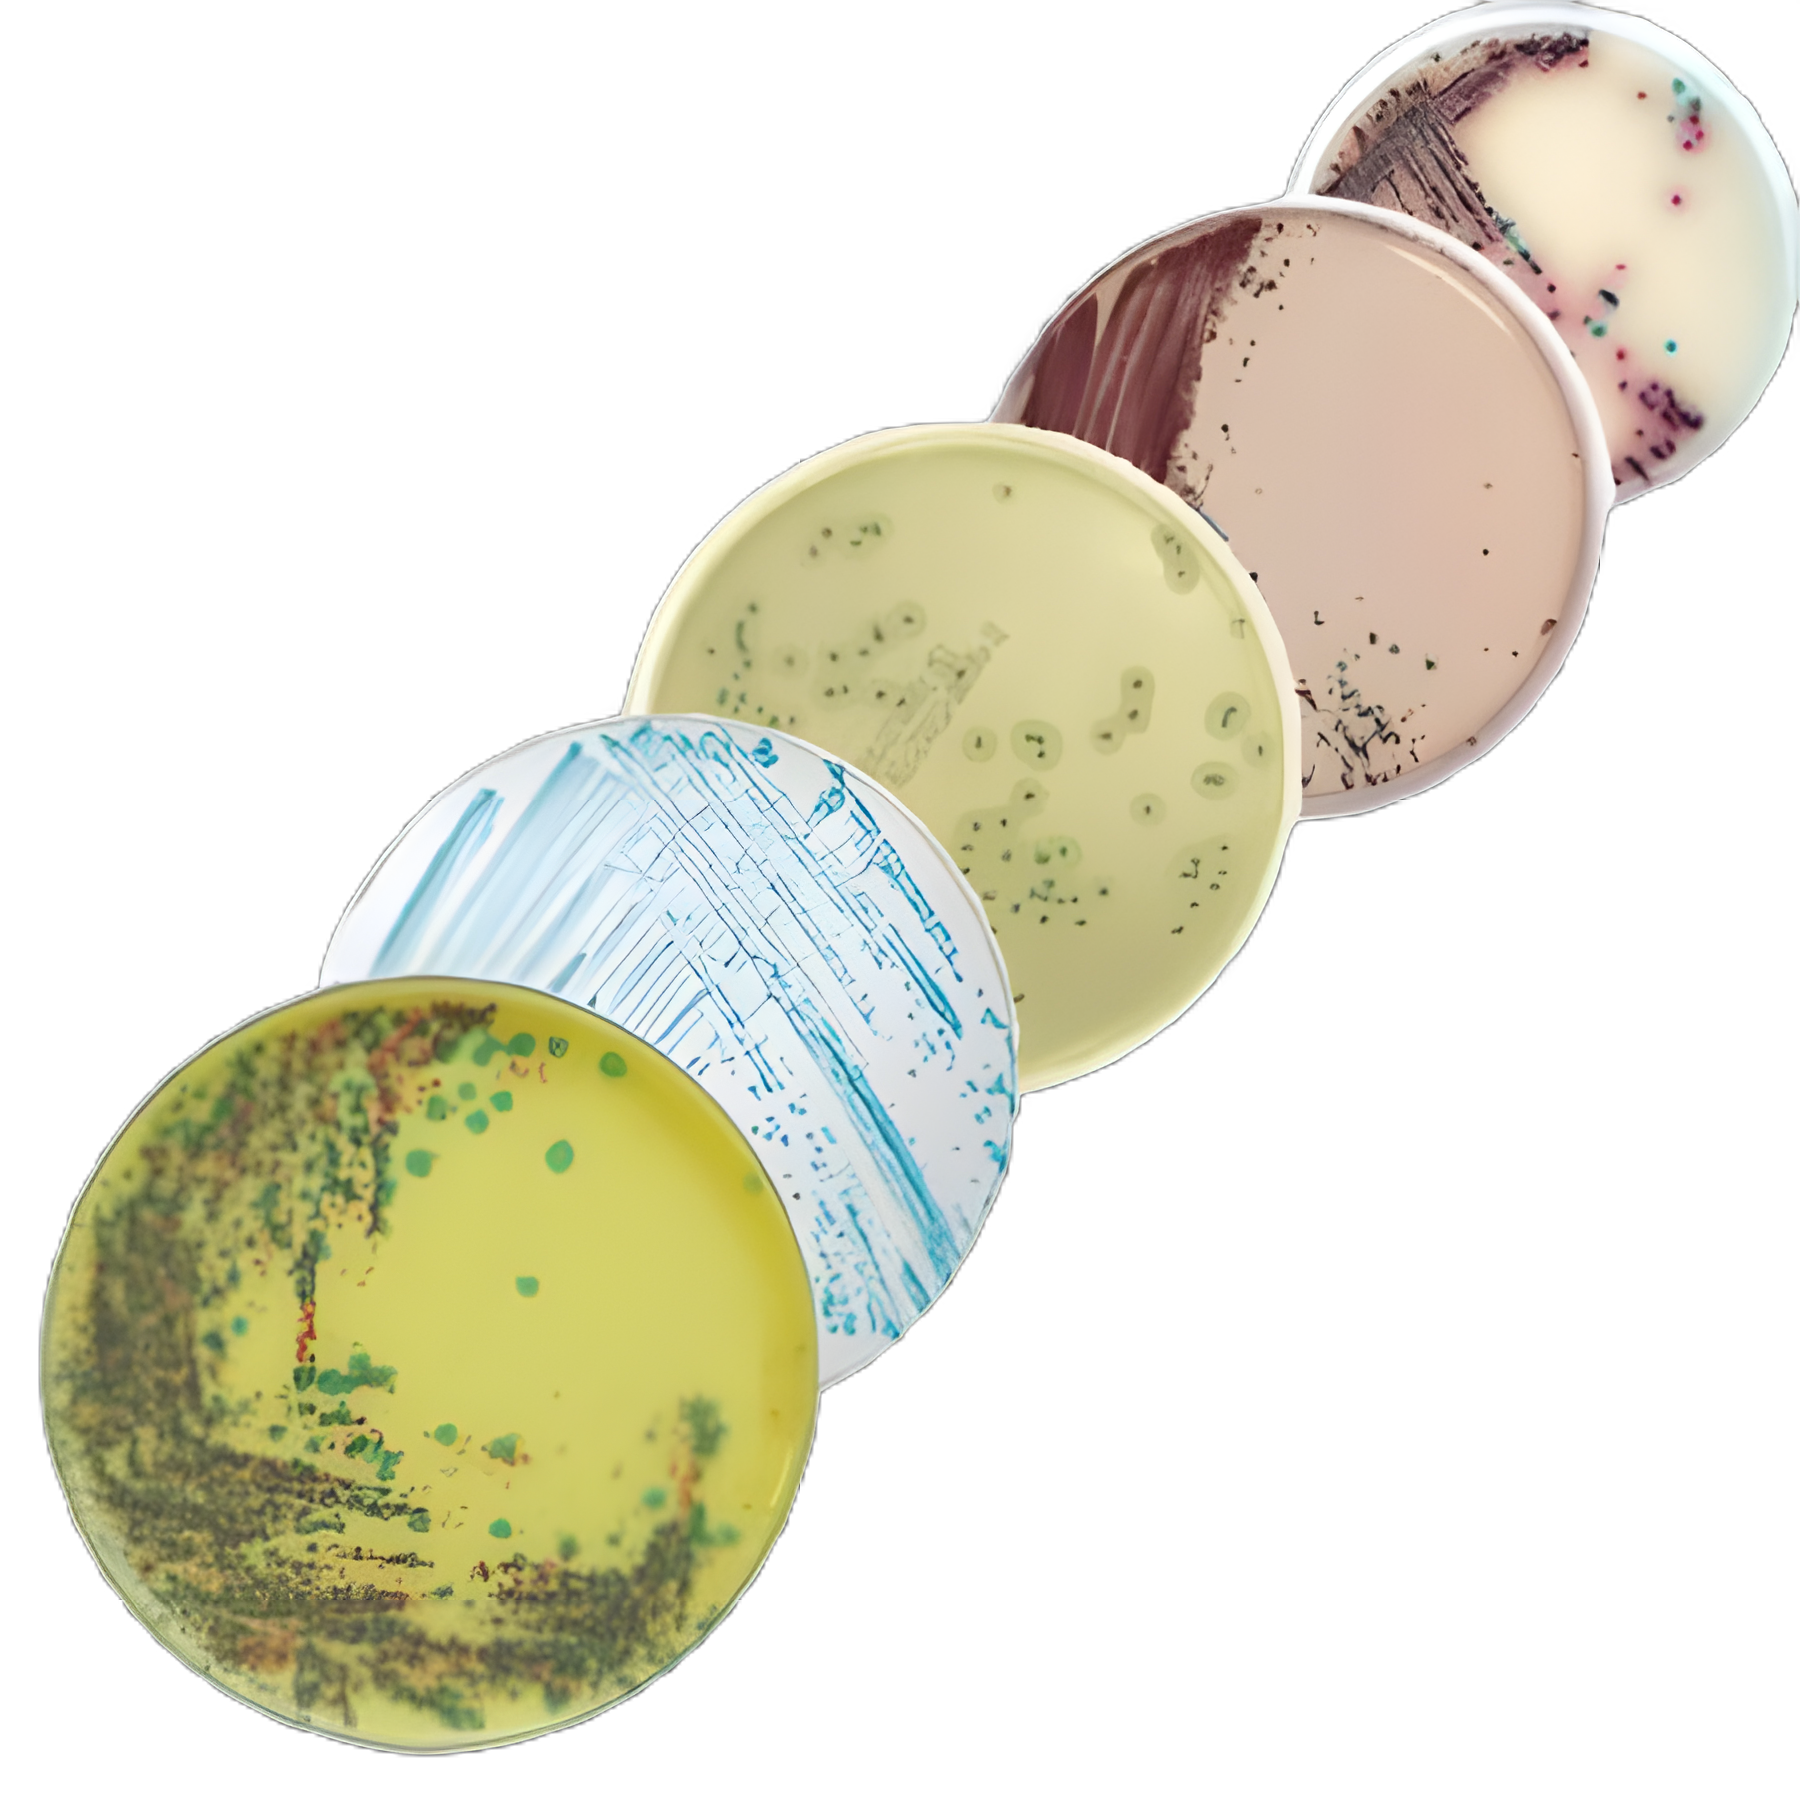

chromID CPS Elite CPSO Agar Mono-Plate for Urine Culture - 418206
418206 | USAMP#32254677
dimensions
Secure Checkout
Verified Supply Chain
Priority Fulfillment
More Information
Locked
Base Price
$87.53
BX
🎯 Unlock Your Custom Tiered Price
15-35% bulk discounts
100+
units
10% OFF
$XX.XX
per unit
Save $XXX
Payment Terms
Priority Shipping
Custom Contract Pricing
250+
units
20% OFF
$XX.XX
per unit
Save $XXX
Payment Terms
Priority Shipping
Custom Contract Pricing
500+
units
30% OFF
$XX.XX
per unit
Save $XXX
Payment Terms
Priority Shipping
Custom Contract Pricing
Unlock Bulk Pricing
See pricing for all volume tiers
Instant access to volume pricing. Register free to compare all tiers and calculate your exact savings.
5,000+ verified buyers
Average savings:$23,400/year
15-35% OFF
for healthcare facilities on bulk orders
24/7 Live Chat!
Instant support anytime
Product Spotlight
- Designed for the isolation, enumeration, and identification of urinary pathogens.
- Direct identification of Escherichia coli and presumptive identification of key bacterial species including Enterococcus, Klebsiella, Enterobacter, Serratia, Citrobacter (KESC), Proteus, Providencia, Morganella (Proteeae).
- Optimized for standardized inoculation methods, enhancing laboratory efficiency and accuracy.
- Manufactured by Biomerieux, ensuring high-quality and reliable results.
- Storage requires refrigeration, maintaining the integrity of the culture medium.